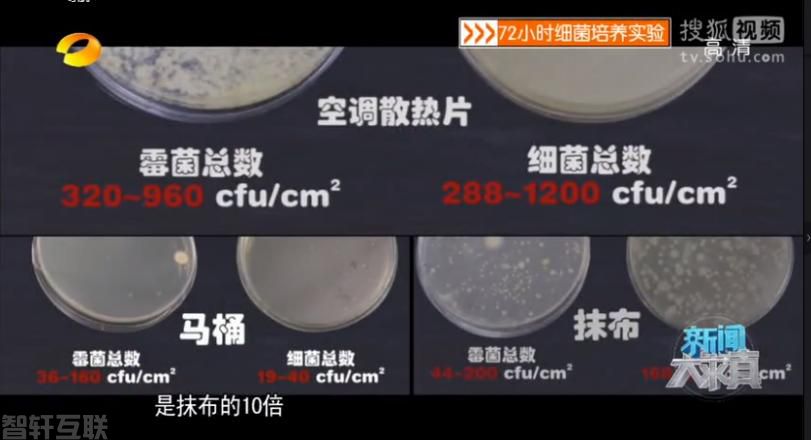

随着天气逐渐升温,家庭里开启空调已成为了避暑的常态. 然而,我们在享受空调带来的清凉的同时,也要警惕吹空调可能带来的健康隐患. 近期,浏阳市人民医院接诊了一位因长时间吹空调而住进呼吸重症监护病房的年轻患者。这位患者因为吹空调而引发感染,严重到需要住进重症监护病房。
这位年轻人名叫小曹(化名),今年26岁. 他因发热、咳嗽以及胸闷气促、呼吸衰竭等症状被紧急送往市人民医院呼吸重症监护病房。小曹的家人表示,他之前已经接受过肺炎的治疗,但效果不佳,发热和咳嗽情况并没有好转,反而出现了胸闷气促等更加严重的症状。医生通过详细询问病史后得知,近期气温升高,小曹连续吹空调了几天,于是考虑到有可能是“空调病”. 经过相关检查,医生的猜测得到了证实,小曹患上了由军团菌感染引起的重症肺炎. 经过三天的抗感染和对症治疗,小曹的症状得到了缓解,他转出了重症监护病房,最终康复出院。
市人民医院呼吸重症监护病房主任石煌介绍说:“最近医院接诊了几例军团菌感染的患者,他们有的是在冷库工作,有的是长时间未清洗的空调引起的. 这些患者大多年轻,病情进展较快. ”军团菌是一种存在于我们周围的潜伏性“杀手”,自然界中常见于水体和土壤中. 未经清洗的空调、花洒、水槽、喷泉等地方都可能成为军团菌的藏身之地. 石煌表示:“如果空调中有藏匿的军团菌,它们会随着冷风被吹出,漂浮在空气中,当人们吸入后就会引发呼吸道感染和发热症状. 严重的情况下,还会导致呼吸衰竭、肾衰竭甚至死亡。”军团菌感染患者的一些症状与新冠肺炎相似,主要影响肺部,还可能引发多器官损害,进而发展为重症,病死率可达5%至30%.

实验节目《新闻大求真》曾进行过一个测试,他们检测了一户人家未经清洗过的空调、马桶和抹布中的细菌数量. 结果发现:空调散热片上的细菌含量是马桶的60倍,是抹布的10倍!也就是说,未经清洗的空调上的细菌比日常生活中的抹布和马桶细菌更多. 而更为重要的是,在空调散热片中还检测出了多种致病菌,包括金黄色葡萄球菌和军团菌等。据调查显示,八成家庭的空调细菌超标. 2014年,中国环境科学学会室内环境与健康分会对上海、北京、深圳等地的家用空调进行了调研,结果发现,88%的空调散热片细菌总数超标. 检测发现,每平方厘米空调散热片上的细菌数量达到了288至1200cfu(cfu指的是单位体积中的活菌个数). 这意味着,空调散热片上的细菌含量是马桶上的60倍。
为了防止空调成为细菌滋生的温床,我们应该定期清洗空调. 清洗空调不仅可以减少细菌滋生的机会,还可以提高空调的使用效率和延长其使用寿命. 同时,在使用空调的时候,重症管理系统应尽量减少过度制冷和吹冷风的时间,保持适宜的室内温度和湿度,避免长时间暴露在冷风中.
总的来说,吹空调可能导致的健康问题是我们需要重视的. 清洗空调、保持适宜的室内环境是预防“空调病”的重要措施. 让我们在夏季享受清凉的同时,也要注意保护健康。
.
咨询在线QQ客服